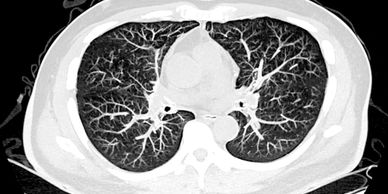

Respiratory Services
Our Philosophy

Breathing is something most of us take for granted—until it becomes difficult. At Dr Lydia Mowlem, our team is dedicated to diagnosing, treating, and managing a wide range of respiratory conditions. With advanced clinical expertise, evidence-based care, and a patient-centred approach, we support individuals to achieve the best possible lung health and quality of life.
Asthma

Asthma is one of the most common chronic respiratory conditions in Australia, affecting both children and adults. Our specialists provide thorough assessments, lung function testing, and personalised treatment plans designed to reduce symptoms, prevent flare-ups, and improve day-to-day wellbeing. We work closely with patients to create asthma action plans that empower them to take control of their health.
Chronic Obstructive Pulmonary Disease (COPD)
Chronic Obstructive Pulmonary Disease (COPD)

COPD is a progressive lung condition that includes emphysema and chronic bronchitis. It can cause persistent cough, mucus production, and breathlessness. Our clinic offers early diagnosis, targeted therapies, and ongoing management strategies to slow disease progression, minimise hospital admissions, and enhance quality of life through pulmonary rehabilitation, smoking cessation support, and medication optimisation.
Lung Cancer
Shortness of Breath (Dyspnoea)
Chronic Obstructive Pulmonary Disease (COPD)

Early detection is critical in lung cancer care. Our team utilizes advanced imaging, diagnostic procedures, and multidisciplinary collaboration to provide accurate assessments and timely interventions. We guide patients through every step of their journey—from diagnosis and staging to treatment planning and follow-up care—ensuring access to the latest therapies and compassionate support.
Lung Nodules
Shortness of Breath (Dyspnoea)
Shortness of Breath (Dyspnoea)
Lung nodules are small growths that may be found incidentally during imaging scans. While most are benign, some can be an early sign of cancer. Our team provides expert evaluation, surveillance, and, when necessary, biopsy or referral to surgical services. With careful monitoring and advanced diagnostic techniques, we deliver peace of mind and early intervention when required.
Shortness of Breath (Dyspnoea)
Shortness of Breath (Dyspnoea)
Shortness of Breath (Dyspnoea)

Breathlessness can arise from a variety of causes, ranging from asthma and COPD to cardiac or other medical conditions. Our team conducts comprehensive assessments to identify underlying causes and develop effective management strategies. We focus on relieving symptoms, improving physical function, and enhancing overall quality of life.
Lung function Testing
Why Choose Dr Lydia Mowlem?
Why Choose Dr Lydia Mowlem?

Lung function tests help diagnose and monitor conditions like asthma, COPD, and other respiratory issues. Tests are non-invasive and performed by trained respiratory scientists.
- Spirometry – Measures how well you can breathe in and out, often before and after a bronchodilator.
- Complex Lung Function – Gives a detailed look at lung capacity, reserve, and gas exchange.
Why Choose Dr Lydia Mowlem?
Why Choose Dr Lydia Mowlem?
Why Choose Dr Lydia Mowlem?

- Specialist expertise in the full spectrum of respiratory diseases
- State-of-the-art diagnostics including lung function testing, bronchoscopy, and advanced imaging
- Personalised care tailored to each patient’s unique needs
- Collaborative approach working alongside GPs, cardiologists, oncologists, and other specialists
- Commitment to patient education empowering individuals to actively manage their respiratory health
At Dr Lydia Mowlem, we believe that every breath matters. Whether you are living with a chronic lung condition or experiencing new respiratory symptoms, our dedicated team is here to provide the highest standard of specialist care.
Copyright © 2026 Dr Lydia Mowlem - All Rights Reserved.
This website uses cookies.
We use cookies to analyze website traffic and optimize your website experience. By accepting our use of cookies, your data will be aggregated with all other user data.